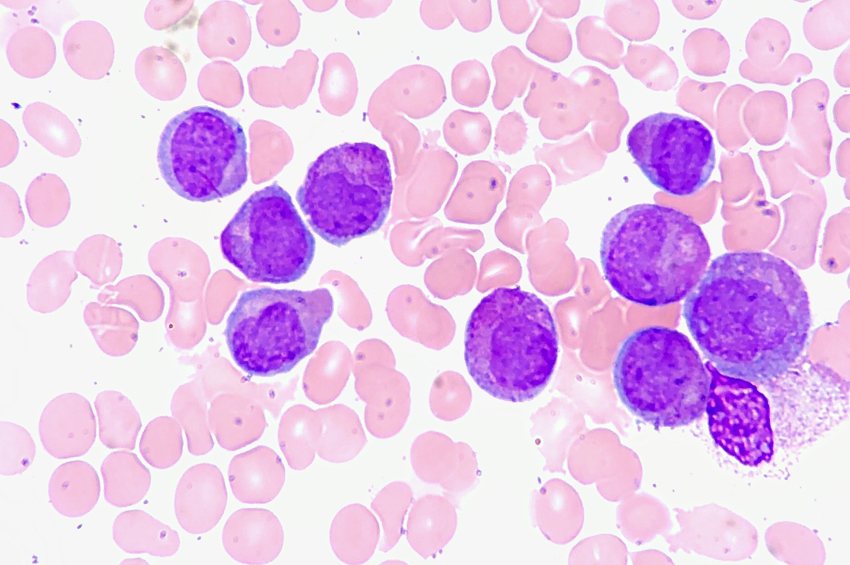

Akut Promyelositik Lösemi (APL) Nedir? Tedavisi
Akut promyelositik lösemi (APL), akut miyeloid löseminin (AML) bir alt tipidir ve benzersiz bir moleküler anormallik ile karakterize edilir. Bu tip lösemi yüksek bir ölüm oranına sahiptir ve erken hemorajik ölümle ilişkilidir.
Haber Merkezi / APL yetişkinlerde nispeten nadirdir ve çocuklar arasında daha yaygındır. APL, kromozom 15 ve 17’nin karşılıklı translokasyonu ile tanımlanır.
Kromozom translokasyonu, bir füzyon transkriptinin promiyelosit (PML) ve retinoik asit reseptör-a (RAR-a) genlerine katılmasına neden olur. Lösemik PML’ler, retinoik aside maruz kaldıklarında farklılaşmaya uğrayabilirken, arsenik trioksite maruz kaldıklarında apoptozun yanı sıra farklılaşmaya da uğrarlar.
Mevcut önerilere göre, yayma morfolojisi ve/veya klinik sunum temelinde APL’den şüphelenildiğinde tıbbi bir acil durum olarak kabul edilir. Trombosit ve kriyopresipitat uygulaması gibi diğer destekleyici önlemlerle birlikte ATRA, genetik tanı beklenirken hemen uygulanır.
Morfoloji
APL hastalarında, periferik kan yayması genellikle azalmış WBC’ler veya dolaşımdaki PML’ler ile lökopeni gösterir. Bu hücrelerde bol miktarda düzensiz birincil azurofilik granül bulunur.
Birden fazla Auer çubuğuna sahip lösemik PML’ler yalnızca APL durumunda bulunur. Nükleer konturun iki lobu vardır, ancak granüllerin varlığı nedeniyle net olarak görülmez. Birçok primer azurofilik granülün varlığı APL tanısını doğrulamayabilir çünkü diğer AML alt tiplerine sahip hastalardan alınan lösemik hücreler de bu tür granüllere sahip olabilir.
Hematologların APL’ye özgü bu ince morfolojik ayrıntıları tam olarak anlamaları gerekir, çünkü şüphelenildiğinde hemen tedavi gerektirir.
APL’nin yönetimi
APL, spesifik moleküler anormalliği hedefleyen terapi yardımıyla tedavi edilebilir. Periferik kan yayması mikroskopla izlenerek tanınabilen çok az malign hematolojik hastalıktan biridir.
APL teşhisinden şüphelenildiğinde, sitogenetik veya moleküler çalışmalarla teşhisin doğrulanması beklenmeden ATRA başlatılır. Başlangıçta, birkaç küçük dozda günde 45 mg/m2’lik standart bir ATRA dozu verilir. Bu, koagülopatiyi kontrol etmeye yardımcı olur.
Düşük riskli hastalarda (yani, WBC <10.000/μL), kemoterapi başlamadan önce ATRA tedavisine birkaç gün devam edilir. Yüksek risk altındaki hastalarda (yani, WBC’ler ≥10.000/μL), ATRA, APL tanısının doğrulanmasından önce bile kemoterapi ile birleştirilir. Alt tipten bağımsız olarak tüm AML vakalarında, genetik doğrulama beklenirken antrasiklin uygulanır.
ATRA’nın kan ürünü desteği ile birlikte erken uygulanmasının ölüm oranlarını azalttığı gösterilmiştir. Halihazırda kullanılan standart tedavi, indüksiyon ve idame sırasında ATRA ile kombine antrasiklin kemoterapisi ve ardından ATRA artı düşük doz kemoterapi gerektirir.
APL tanısı yeni konan hastalarda ATRA tedavisini arsenik trioksit ile kombine etmek daha etkili bir yaklaşımdır. Lökositozu kontrol altında tutmak için kemoterapiye minimal düzeyde devam edilebilir. Bu yeni yaklaşım, gelecekte geleneksel yöntemlerin yerini alabilir. AML’nin diğer alt tiplerden farklı olduğu ve acil ve agresif tıbbi müdahale gerektirdiği unutulmamalıdır.
Dikkat: Sayfa içeriği sadece bilgilendirme amaçlıdır.






























